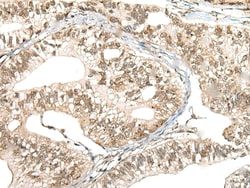
Invitrogen CCNK Polyclonal Antibody 100 &mu;L; Unconjugated:Anticuerpos

missing translation for 'onlineSavingsMsg'
Learn More
Learn More
Invitrogen™ CCNK Polyclonal Antibody


Rabbit Polyclonal Antibody
Marca: Invitrogen™ PA568387
Este artículo no se puede devolver.
Vea la política de devoluciones
Descripción
CCNK Polyclonal Antibody for Western Blot, IHC (P)
Regulatory subunit of cyclin-dependent kinases that mediates activation of target kinases. Plays a role in transcriptional regulation via its role in regulating the phosphorylation of the C-terminal domain (CTD) of the large subunit of RNA polymerase II (POLR2A).
Especificaciones
| CCNK | |
| Polyclonal | |
| Unconjugated | |
| CCNK | |
| AW123198; AW413594; CCNK; CPR4; CycK; cyclin K; cyclin-K | |
| Rabbit | |
| Antigen affinity chromatography | |
| RUO | |
| 8812 | |
| -20°C | |
| Liquid |
| Immunohistochemistry (Paraffin), Western Blot | |
| 0.4 mg/mL | |
| PBS with 40% glycerol and 0.05% sodium azide; pH 7.4 | |
| O75909 | |
| CCNK | |
| Synthetic protein corresponding to residues near the C terminal of human CCNK. | |
| 100 μL | |
| Primary | |
| Human | |
| Antibody | |
| IgG |
Corrección del contenido de un producto
Proporcione sus comentarios sobre el contenido del producto rellenando el siguiente formulario.
Título del producto
¿Detecta una oportunidad de mejora?Comparta una corrección de contenido